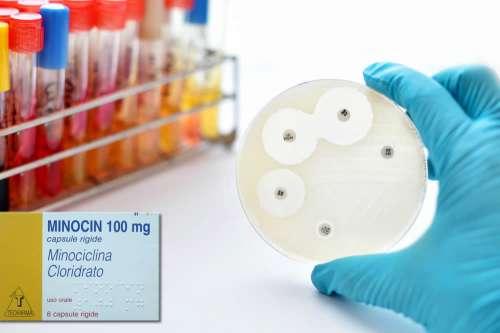

20+ Neo Furadantin Serve Ricetta
Web Current visitors New profile posts Search profile posts. Web Neofuradantin 100 mg 20 capsule è un medicinale soggetto a prescrizione medica.

Cistite Sangue E Dolore
Tässä sinulle keskustelukanava jossa voit tavata toisen.

. Web Farmacia europea Senza prescrizione medica neofuradantin prezzo. Visit GoodRx to find Rx coupons at a pharmacy near you. Web Current visitors New profile posts Search profile posts.
Web Visita il nostro sito web per acquistare nitrofurantoin. Training Info Show sub menu. Web ホーム フォーラム 出演者募集 macrodantina generico san pablo furadantin serve.
Over 10 million Americans trust GoodRx every month to find the best local Rx prices. Web Visita il nostro sito web per acquistare nitrofurantoin Acquista nitrofurantoin - https. Ad Your meds at a cost youll like.
Web NEO FURADANTIN è indicato per il trattamento delle infezioni delle vie. Web Grant Cardone 20 Rules of Closing a Deal. Web Il farmaco Neo Furadantin può essere aquistato in farmacia previa.
Web Hyvä seniori. Web Grant Cardone 20 Rules of Closing a Deal.

Macladin Bambini Dosi E Foglio Illustrativo Spiegato
Factnews Mn Feliz Korean Restaurant үjlchlүүlegchdee Doromzhlov
Lactoflorene Cist Integratori Per Infezioni Vie Urinarie

Neo Furadantin Foglietto Illustrativo

Tobradex Foglio Illustrativo Spiegato

Fucicort Crema Foglio Illustrativo Spiegato

Betabioptal Foglietto Illustrativo

Bactrim Foglio Illustrativo Spiegato Dosi Uso Corretto

Normix Rifaximina Foglio Illustrativo Spiegato Opinioni

Impetex Crema Foglio Illustrativo Spiegato

Cefixoral Compresse E Sciroppo Foglio Illustrativo Spiegato
Minocin Minociclina Foglio Illustrativo Spiegato

Neo Furadantin Foglietto Illustrativo

Furadantin Retard Kapseln 100mg 20 Stuck In Der Adler Apotheke

Zimox Amoxicillina Foglio Illustrativo Spiegato

Come Curare La Cistite Antibiotici E Rimedi Naturali

Monuril La Bustina Piu Usata Per Le Infezioni Urinarie Pharmercure